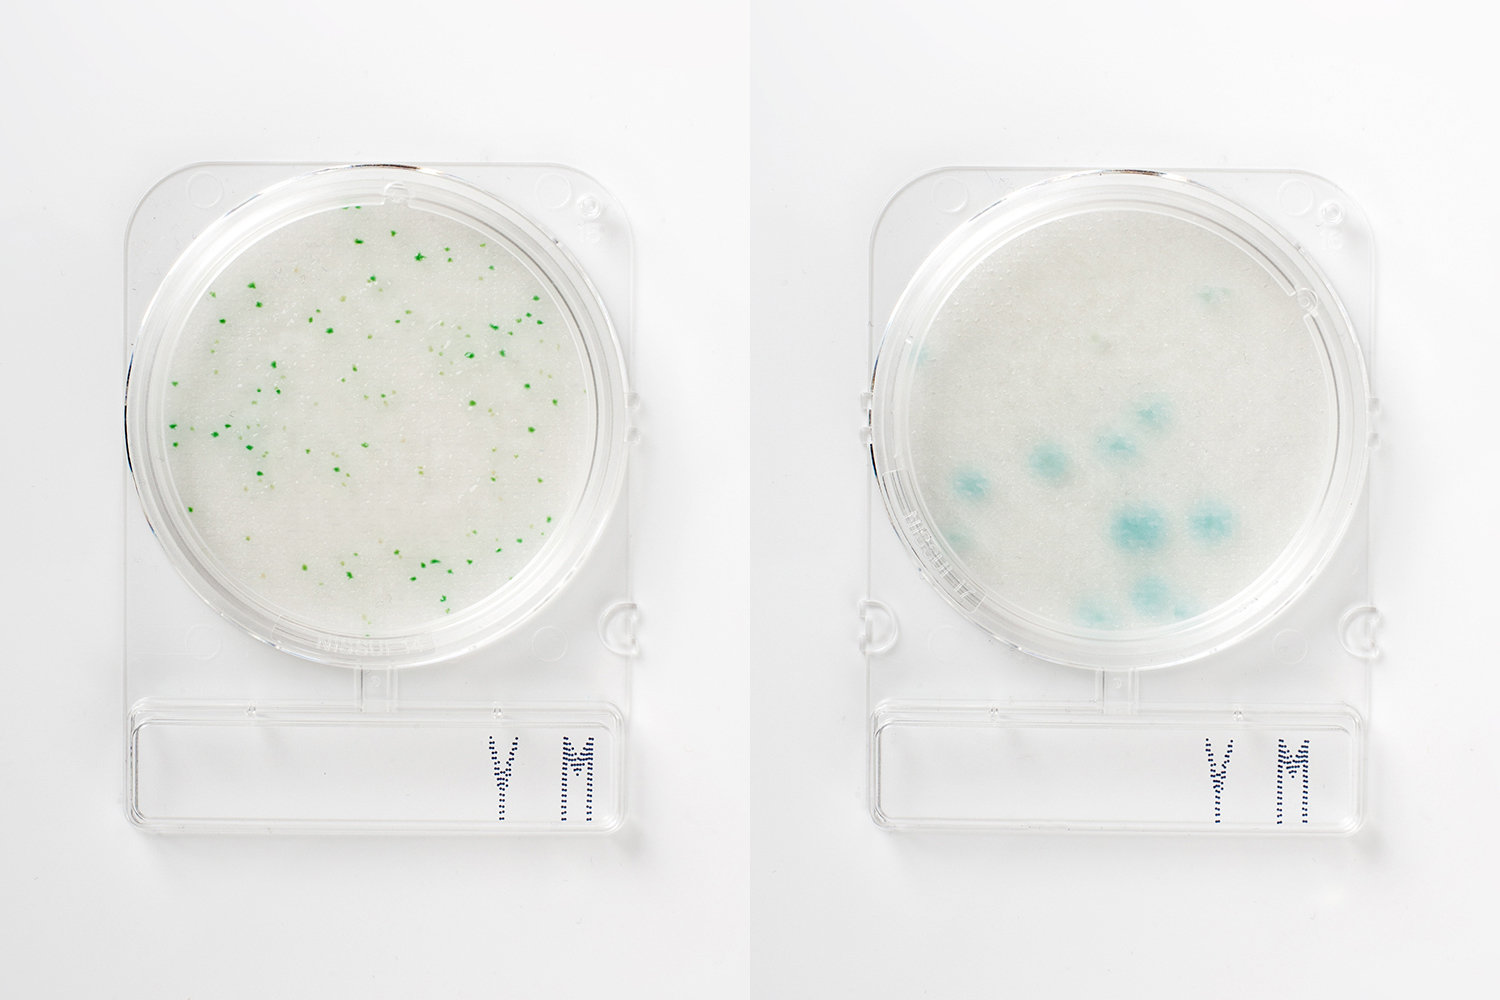

Compact Dry™ Prepared Media Plates - 54054
Compact Dry™ is a simple and safe procedure to determine and quantify microorganisms in food and beverage, raw materials, cosmetics and pharmaceutical industries and internal environmental monitoring. The ready-to-use Compact Dry™ chromogenic plates are suitable for both in-process and final product controls.
- Ready-to-use
- Self-diffusing media - no need for a spreader
- Room temperature storage vs competitive products with storage at temperatures less than or equal to 8ºC
- Rigid transparent plates with removable lid - no leakage
- Innovative stacking design
- Easy to label
- Ability to subculture without damage to colonies
- Widest available parameters and broadest application
- Convenient, fast and accurate results
Yeast and mold display different colony morphology and color due to the chromogenic substrate present in the media. X-Phos is degraded by growing yeast presenting a blue coloration of the colony, yeast will appear as blue or cream colonies. Bacterial growth is inhibited by antibiotics. The head space in the Compact Dry™ plate allows mold to develop their characteristic filamentous shape due to growing mycelium.
You've got questions, we've got answers.
Reach out and let's see what we can do together.